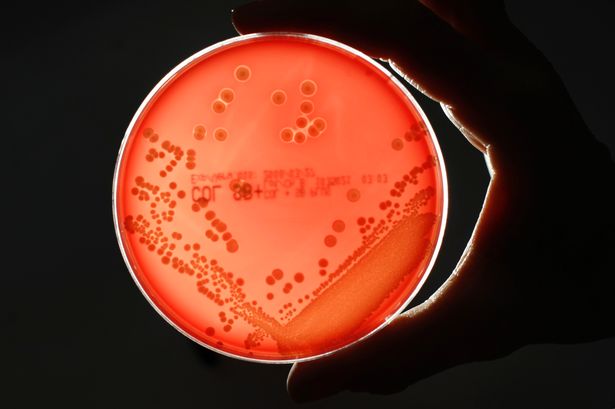

Archive for May, 2013
Keeping VA’s Food Banks Stocked for Summer
Posted by Virginia Public Radio in Daily Capitol News Updates on May 31, 2013
 Hunger pangs may be a sign to raid the refrigerator, order carryout, heat up some leftovers, or head to your favorite restaurant. But thousands of Virginia children don’t have that option. In fact—and it’s a little-known fact—area food banks throughout the Commonwealth are in greater need of supplies over the summer than over the holidays, when most food drives take place. Virginia Public Radio’s Tommie McNeil has more details.
Hunger pangs may be a sign to raid the refrigerator, order carryout, heat up some leftovers, or head to your favorite restaurant. But thousands of Virginia children don’t have that option. In fact—and it’s a little-known fact—area food banks throughout the Commonwealth are in greater need of supplies over the summer than over the holidays, when most food drives take place. Virginia Public Radio’s Tommie McNeil has more details.
Joint Appearance by VA’s Gubernatorial Candidates
Posted by Virginia Public Radio in Daily Capitol News Updates on May 31, 2013
 In a rare joint appearance, Virginia’s major-party gubernatorial candidates appeared on the same stage, albeit very briefly. But Attorney General Ken Cuccinelli and Terry McAuliffe seemed to respect one another, while also describing their definition of transparency and open government—the theme for the Virginia Public Access Project luncheon. As Virginia Public Radio’s Tommie McNeil reports, while they both have support for business and economic development in common, they are far apart on many other issues.
In a rare joint appearance, Virginia’s major-party gubernatorial candidates appeared on the same stage, albeit very briefly. But Attorney General Ken Cuccinelli and Terry McAuliffe seemed to respect one another, while also describing their definition of transparency and open government—the theme for the Virginia Public Access Project luncheon. As Virginia Public Radio’s Tommie McNeil reports, while they both have support for business and economic development in common, they are far apart on many other issues.
Virginia Conversations: Project Discovery
Posted by Virginia Public Radio in Virginia Conversations on May 31, 2013

Haley Almarode (l), Jonathan Thomas, and Zoe Helmandollar (r) received scholarships from Project Discovery
On this edition of the program– keeping students on track to a more successful education. Our guests are from Project Discovery – a program designed to help students graduate from high school and continue with a college education. May-Lily Lee hosts, as we learn how it works and how to take part in the program, as well as hear from some students who are benefiting from it.
Additional Resources: Project Discovery
Virginia Department of Education: Virginia is for Lovers….of Summer Learning!
Flora of Virginia
Posted by Virginia Public Radio in Virginia's News on May 30, 2013
Chinese Meat Processor Takes Smithfield Foods
Posted by Virginia Public Radio in Virginia's News on May 29, 2013
Smithfield Foods is being sold to China’s largest pork producer. Beverly Amsler reports on the $4.7 billion deal.
Governor Expedites Rights Restoration Process
Posted by Virginia Public Radio in Daily Capitol News Updates on May 29, 2013
 Although the General Assembly this year shot down one opportunity for Governor McDonnell to fulfill a campaign promise to restore the voting and civil rights of nonviolent felons, the Governor has found a way to sidestep lawmakers and make progress toward that goal. A day after Attorney General Ken Cuccinelli unveiled his advisory report on the issue, McDonnell announced his own initiative. And as Virginia Public Radio’s Tommie McNeil reports, it does not require amending the state Constitution.
Although the General Assembly this year shot down one opportunity for Governor McDonnell to fulfill a campaign promise to restore the voting and civil rights of nonviolent felons, the Governor has found a way to sidestep lawmakers and make progress toward that goal. A day after Attorney General Ken Cuccinelli unveiled his advisory report on the issue, McDonnell announced his own initiative. And as Virginia Public Radio’s Tommie McNeil reports, it does not require amending the state Constitution.
Virginia Poverty Measure
Posted by Virginia Public Radio in Virginia's News on May 29, 2013
Cubs on Camera
Posted by Virginia Public Radio in Virginia's News on May 29, 2013
It’s spring, and that means business for the Wildlife Center of Virginia, where hundreds of animals – many of them babies — are brought for treatment of injuries or illness. This year veterinarians are caring for a record number of bear cubs, and as Sandy Hausman reports, the public is invited to watch.
Restoration of Rights
Posted by Virginia Public Radio in Daily Capitol News Updates on May 28, 2013
 Virginia Attorney General Ken Cuccinelli has unveiled a list of options that would expedite the process of voting-rights restoration for non-violent felons. The proposals were made by a bipartisan advisory panel he created after a rights-restoration amendment to the state Constitution that he endorsed failed to pass the General Assembly this year. And as Virginia Public Radio’s Anne Marie Morgan reports, the Attorney General says Governors can and should do more to intervene.
Virginia Attorney General Ken Cuccinelli has unveiled a list of options that would expedite the process of voting-rights restoration for non-violent felons. The proposals were made by a bipartisan advisory panel he created after a rights-restoration amendment to the state Constitution that he endorsed failed to pass the General Assembly this year. And as Virginia Public Radio’s Anne Marie Morgan reports, the Attorney General says Governors can and should do more to intervene.
Meantime, Democrats aren’t buying the Attorney General’s change of heart. They accuse him of playing election -year politics as he campaigns for Governor.
VaNews for 05.28.13
Posted by Virginia Public Radio in VaNews from VPAP on May 28, 2013
 Stories about political pressure on state universities to hold down tuition and some movement toward offshore wind energy development were among the most clicked this past week at the Virginia Public Access Project’s VaNews link on vpap.org.
Stories about political pressure on state universities to hold down tuition and some movement toward offshore wind energy development were among the most clicked this past week at the Virginia Public Access Project’s VaNews link on vpap.org.
VA Tribes Fighting for Federal Recognition
Posted by Virginia Public Radio in Virginia's News on May 28, 2013
Cicadas on the Menu
Posted by Virginia Public Radio in Virginia's News on May 24, 2013
As the 17-year cicadas emerge from the ground, millions of birds will be feasting – and a few people plan to join the party, harvesting, cooking and eating these insects which experts say are high in protein, low in fat and cholesterol. Sandy Hausman was at one of the first dinner parties to celebrate the coming of cicadas.
Experts say that due to the prolific use of pesticides it is not recommended to eat any bug without knowing its origins are safe.
Tax Dept Debit Cards
Posted by Virginia Public Radio in Virginia's News on May 24, 2013
 Those debit cards that the Virginia Department of Taxation issued to taxpayers instead of checks are NOT going anywhere. In fact, as the tax season wraps up, most residents have already seen them. But as Virginia Public Radio’s Tommie McNeil reports, Tax Commissioner Craig Burns has told the Senate Finance Committee that he believes the worst is over.
Those debit cards that the Virginia Department of Taxation issued to taxpayers instead of checks are NOT going anywhere. In fact, as the tax season wraps up, most residents have already seen them. But as Virginia Public Radio’s Tommie McNeil reports, Tax Commissioner Craig Burns has told the Senate Finance Committee that he believes the worst is over.
Virginia Conversations: The Gubernatorial Race
Posted by Virginia Public Radio in Virginia Conversations on May 24, 2013

Terry McAuliffe (left) and Ken Cuccinelli (right)
On this edition of “Virginia Conversations,” a discussion on the race for Governor between Republican Ken Cuccinelli and Democrat Terry McAuliffe. Our political pundits weigh in on the issues facing… and dogging, the two candidates. Plus we’ll have reaction to last weekend’s GOP convention in Richmond. Join host May-Lily Lee.
Election Rules Reminder
Posted by Virginia Public Radio in Daily Capitol News Updates on May 22, 2013
 As the statewide and local campaigns heat up and we move closer to a Democratic Primary, the State Board of Elections wants to remind citizens of a number of rules to remember regarding voter and candidate ethics. As Virginia Public Radio’s Tommie McNeil reports, the Board takes seriously state code violations which could result in fines or other penalties.
As the statewide and local campaigns heat up and we move closer to a Democratic Primary, the State Board of Elections wants to remind citizens of a number of rules to remember regarding voter and candidate ethics. As Virginia Public Radio’s Tommie McNeil reports, the Board takes seriously state code violations which could result in fines or other penalties.
Online Tax Tangles
Posted by Virginia Public Radio in Virginia's News on May 22, 2013
Today’s Consumer
Posted by Virginia Public Radio in Virginia's News on May 22, 2013
State Employees See Health Insurance Changes
Posted by Virginia Public Radio in Daily Capitol News Updates on May 21, 2013
Tens of thousands of state employees will likely see an increase in the cost of their health insurance plans beginning July 1st. They also face a deadline this week, as the Commonwealth begins to implement significant changes in its health insurance plans. Open enrollment for revising health benefits, investing in flexible spending accounts, adding family members, and other options ends this Friday. Virginia Public Radio’s Anne Marie Morgan reports, reductions in premiums could await those who enroll in a new Wellness Engine called “MyActiveHealth.”
Virginia Scientists Predict a Breakthrough in Cancer Treatment
Posted by Virginia Public Radio in Virginia's News on May 21, 2013
Scientists at the University of Virginia have made a surprising discovery that could mean more effective treatments for a range of deadly cancers. Sandy Hausman reports on how this finding could shape future therapies, and how long it might take to bring those to market.
State Revenues Still a Concern for Lawmakers
Posted by Virginia Public Radio in Daily Capitol News Updates on May 21, 2013
 State revenues improved a little last month following a dismal drop of 6.1% in March. The news reassured members of the House Appropriations Committee, who worry that federal sequestration cuts could have a negative impact on both Virginia’s economy and the state’s coffers. As Virginia Public Radio’s Anne Marie Morgan reports, the Commonwealth’s Secretary of Finance confirmed that they have good reason for concern.
State revenues improved a little last month following a dismal drop of 6.1% in March. The news reassured members of the House Appropriations Committee, who worry that federal sequestration cuts could have a negative impact on both Virginia’s economy and the state’s coffers. As Virginia Public Radio’s Anne Marie Morgan reports, the Commonwealth’s Secretary of Finance confirmed that they have good reason for concern.
VaNews for 05.21.13
Posted by Virginia Public Radio in VaNews from VPAP on May 21, 2013
 A University of Virginia history class that attracted 47,000 students and a look at the career of entrepreneur and politicans’ friend Jonnie Williams were the topics two of the most-read stories over the past week at the Virginia Public Access Project’s VaNews link on vpap.org. Fred Echols reports.
A University of Virginia history class that attracted 47,000 students and a look at the career of entrepreneur and politicans’ friend Jonnie Williams were the topics two of the most-read stories over the past week at the Virginia Public Access Project’s VaNews link on vpap.org. Fred Echols reports.
VaNews is a free public service of the Virginia Public Access Project and can be found at vpap.org
Learning to Learn
Posted by Virginia Public Radio in Virginia's News on May 17, 2013
Republican Convention in Richmond
Posted by Virginia Public Radio in Daily Capitol News Updates on May 17, 2013
More than 13,000 GOP convention delegates have converged on Richmond from all over the state to confirm Attorney General Ken Cuccinelli as the party’s gubernatorial nominee—and to nominate their candidates for Lieutenant Governor and Attorney General on Saturday. Virginia Public Radio’s Tommie McNeil talked with some of them to find out why they’re delegates, what they expect to hear Saturday, and who they’re supporting. 
Virginia Conversations: Sen. Mark Warner
Posted by Virginia Public Radio in Virginia Conversations on May 17, 2013
 On this edition of Virginia Conversations, an hour with Virginia Senator, and former Governor, Mark Warner.
On this edition of Virginia Conversations, an hour with Virginia Senator, and former Governor, Mark Warner.
He organized the so-called “Gang of Six” to end the partisan gridlock in the Senate. We’ll ask him how those efforts are going today… and get his take on other domestic and foreign issues as well.
Join host May-Lily Lee.
Liberty University Continues Fight Against Health Care Law
Posted by Virginia Public Radio in Daily Capitol News Updates on May 16, 2013
 Liberty University is once again rolling the dice by asking a three-judge panel appointed by Presidents Clinton and Obama to side with the Christian-based college against some of the mandates in the Affordable Care Act. The 4th U.S. Circuit Court of Appeals panel pointed out that Liberty’s case is broader than other, similar suits. Virginia Public Radio’s Tommie McNeil reports that some judges questioned whether it’s premature since all regulations have not yet gone into effect.
Liberty University is once again rolling the dice by asking a three-judge panel appointed by Presidents Clinton and Obama to side with the Christian-based college against some of the mandates in the Affordable Care Act. The 4th U.S. Circuit Court of Appeals panel pointed out that Liberty’s case is broader than other, similar suits. Virginia Public Radio’s Tommie McNeil reports that some judges questioned whether it’s premature since all regulations have not yet gone into effect.
Governor McDonnell’s Job Approval Rating
Posted by Virginia Public Radio in Daily Capitol News Updates on May 15, 2013
 A new Quinnipiac poll gauges where Virginia voters stand on Governor Bob McDonnell in light of the relationship between McDonnell and Star Scientific CEO Jonnie Williams, who paid for wedding catering for the Governor’s daughter. As Virginia Public Radio’s Tommie McNeil reports, the poll suggests that the Governor has taken a popularity hit—but not enough right now to threaten his political career.
A new Quinnipiac poll gauges where Virginia voters stand on Governor Bob McDonnell in light of the relationship between McDonnell and Star Scientific CEO Jonnie Williams, who paid for wedding catering for the Governor’s daughter. As Virginia Public Radio’s Tommie McNeil reports, the poll suggests that the Governor has taken a popularity hit—but not enough right now to threaten his political career.
Virginia’s Endangered Places
Posted by Virginia Public Radio in Virginia's News on May 15, 2013

The Compton-Bateman House in Better Days
Preservation Virginia’s 2013 list of endangered places ranges from 12 acres of old growth hardwoods to century-old schools built for Africa American students. The sites on the list are threatened by development, neglect and a lack of funding. Tim Thornton reports.
Date Set in Chef’s Embezzlement Case
Posted by Virginia Public Radio in Daily Capitol News Updates on May 15, 2013
 A Richmond judge has set a trial date for the felony embezzlement case of former Executive Mansion chef Todd Schneider, who is accused of stealing food from the residence. Schneider also catered the wedding of Governor McDonnell’s daughter, and his descriptions of the relationships between Star Scientific CEO Jonnie Williams, the McDonnell family, and Attorney General Ken Cuccinelli have prompted new investigations but no new charges. Virginia Public Radio’s Anne Marie Morgan has more details from the courthouse in Richmond.
A Richmond judge has set a trial date for the felony embezzlement case of former Executive Mansion chef Todd Schneider, who is accused of stealing food from the residence. Schneider also catered the wedding of Governor McDonnell’s daughter, and his descriptions of the relationships between Star Scientific CEO Jonnie Williams, the McDonnell family, and Attorney General Ken Cuccinelli have prompted new investigations but no new charges. Virginia Public Radio’s Anne Marie Morgan has more details from the courthouse in Richmond.
Scientists Makes Political Endorsement
Posted by Virginia Public Radio in Virginia's News on May 14, 2013
Lawmakers Weigh In Red Flags & Abuse
Posted by Virginia Public Radio in Virginia's News on May 14, 2013
The Run for Lieutenant Governor: Susan Stimpson
Posted by Virginia Public Radio in Candidate Profiles on May 13, 2013
 More than 13,000 Republicans are preparing to gather in Richmond for their state nominating convention that begins on Friday. They will choose their nominees for Lieutenant Governor and Attorney General—and given the large field, many say it’s been challenging to select only one for each office. In the last installment of our election series on the statewide candidates, Virginia Public Radio’s Anne Marie Morgan reports on the final contender, Susan Stimpson—who is one of two women vying for Lieutenant Governor.
More than 13,000 Republicans are preparing to gather in Richmond for their state nominating convention that begins on Friday. They will choose their nominees for Lieutenant Governor and Attorney General—and given the large field, many say it’s been challenging to select only one for each office. In the last installment of our election series on the statewide candidates, Virginia Public Radio’s Anne Marie Morgan reports on the final contender, Susan Stimpson—who is one of two women vying for Lieutenant Governor.
New Approach to Stopping Superbugs
Posted by Virginia Public Radio in Virginia's News on May 13, 2013
The Run for Lieutenant Governor: Ralph Northam & Aneesh Chopra
Posted by Virginia Public Radio in Candidate Profiles on May 13, 2013
Today we round out our election series on the statewide candidates, focusing on the two Democrats running for Lieutenant Governor in the June 11thprimary. State Senator Ralph Northam and former Obama Administration Chief Technology Officer Aneesh Chopra have distinct backgrounds. Virginia Public Radio’s Tommie McNeil reports both contenders say their goal is to govern Virginia in a slightly different direction than the current administration.
The Run for Lieutenant Governor: Steve Martin & Corey Stewart
Posted by Virginia Public Radio in Candidate Profiles on May 13, 2013
We continue today with Part 7 of our election series on the statewide candidates with a focus on the crowded GOP Lieutenant Governor’s race Virginia Public Radio’s Tommie McNeil reports on a veteran state lawmaker and a local government leader who are both seeking the nomination: Chesterfield Senator Steve Martin and Prince William Board of Supervisor Chair Corey Stewart.
The Run for Lieutenant Governor: E.W. Jackson and Pete Snyder
Posted by Virginia Public Radio in Candidate Profiles on May 13, 2013
Among the seven candidates seeking to become the Republicans’ nominee for Lieutenant Governor two have no public office experience. But, from their point-of-view, that’s a good thing. Virginia Public Radio’s Anne Marie Morgan introduces us to the only African-American running for Lieutenant Governor this year and a Northern Virginia businessman: E.W. Jackson and Pete Snyder.
VaNews for 05.13.13
Posted by Virginia Public Radio in VaNews from VPAP on May 13, 2013
 One of Virginia’s worst political scandals is back in the headlines while a statewide political race that usually gets little attention will be in the spotlight this year. Those stories have been among the the most read this past week on the Virginia Public Access Project’s VaNews at VPAP.org. Fred Echols reports.
One of Virginia’s worst political scandals is back in the headlines while a statewide political race that usually gets little attention will be in the spotlight this year. Those stories have been among the the most read this past week on the Virginia Public Access Project’s VaNews at VPAP.org. Fred Echols reports.
VaNews is a free public service of the Virginia Public Access Project and can be found at vpap.org.
Fracking in the GW National Forest
Posted by Virginia Public Radio in Virginia's News on May 10, 2013
Virginia Conversations: The State’s Wine Industry
Posted by Virginia Public Radio in Virginia Conversations on May 10, 2013
 In this program, we look at how the state’s vineyards are doing, talk to the man dubbed “The Father of the Modern Virginia Wine Industry”, and hear from two distinguished wine critics on how Virginia’s wines measure up with host May-Lily Lee.
In this program, we look at how the state’s vineyards are doing, talk to the man dubbed “The Father of the Modern Virginia Wine Industry”, and hear from two distinguished wine critics on how Virginia’s wines measure up with host May-Lily Lee.
Here’s a link to some upcoming Virginia wine events.
The Run for Lieutenant Governor: Ligamfelter & Davis
Posted by Virginia Public Radio in Candidate Profiles on May 8, 2013
 Nine candidates are seeking their party’s nominations for Lieutenant Governor this year. The first in our profile formerly served as state Delegate and state Senator and is one of only two women to run for statewide office during this nominating season, Jeannemarie Davis. The second in this first part of our series is former Army Colonel and long-time Delegate, Scott Lingamfelter. Anne Marie Morgan reports.
Nine candidates are seeking their party’s nominations for Lieutenant Governor this year. The first in our profile formerly served as state Delegate and state Senator and is one of only two women to run for statewide office during this nominating season, Jeannemarie Davis. The second in this first part of our series is former Army Colonel and long-time Delegate, Scott Lingamfelter. Anne Marie Morgan reports.
Political Fallout
Posted by Virginia Public Radio in Virginia's News on May 7, 2013
Senator Mark Herring Running for Attorney General
Posted by Virginia Public Radio in Candidate Profiles on May 6, 2013
 More than six years into his career as a State Senator, Mark Herring believes it’s now time to transition into a higher office—as Virginia’s next Attorney General.
More than six years into his career as a State Senator, Mark Herring believes it’s now time to transition into a higher office—as Virginia’s next Attorney General.
He’s one of only two Democrats running for the office, which he says has been held too long by Republicans. In Part 4 of our election series, Virginia Public Radio’s Tommie McNeil introduces us to the Senator from Loudoun County, who’s seeking the Democratic nomination in the June 11th primary.
VaNews for 05.06.13
Posted by Virginia Public Radio in VaNews from VPAP on May 6, 2013
 One method of paying for new roads in Virginia has hit a speed bump and a Hampton Roads man is in trouble for roughing up a city councilman’s car. Those were two of the most clicked stories at the Virginia Public Access Project’s VaNews link. Fred Echols reports.
One method of paying for new roads in Virginia has hit a speed bump and a Hampton Roads man is in trouble for roughing up a city councilman’s car. Those were two of the most clicked stories at the Virginia Public Access Project’s VaNews link. Fred Echols reports.
VaNews is a free public service of the Virginia Public Access Project and can be found at vpap.org.
Virginia Lawmakers on Immigration Debate
Posted by Virginia Public Radio in Virginia's News on May 6, 2013
Justin Fairfax Running for Attorney General
Posted by Virginia Public Radio in Candidate Profiles on May 3, 2013
On June 11th, ALL registered voters in the Commonwealth will be able to participate in a Democratic primary to choose the party’s candidates for Lieutenant Governor and Attorney General. In Part 3 of our election series, Virginia Public Radio’s Tommie McNeil reports on a small business-owner and former federal prosecutor who is seeking the Democratic nomination for Attorney General: Justin Fairfax.
Virginia Conversations: Early Childhood Education
Posted by Virginia Public Radio in Virginia Conversations on May 3, 2013
 We’re talking about early childhood education on this edition of “Virginia Conversations”– early childhood education. Many believe it’s the key to succeeding in school, a career… even life itself. But not every child has the best opportunity to receive that all-important early start. So, what’s being done at the local and state levels to help kids get off on the right foot? May-Lily Lee and her guests look for some answers.
We’re talking about early childhood education on this edition of “Virginia Conversations”– early childhood education. Many believe it’s the key to succeeding in school, a career… even life itself. But not every child has the best opportunity to receive that all-important early start. So, what’s being done at the local and state levels to help kids get off on the right foot? May-Lily Lee and her guests look for some answers.
Former Chef Fights Back
Posted by Virginia Public Radio in Daily Capitol News Updates on May 3, 2013
 Norfolk Commonwealth’s Attorney Gregory Underwood will now handle the state embezzlement case of a former Executive Mansion chef. That’s because a Richmond circuit court judge has agreed to Attorney General Ken Cuccinelli’s request to withdraw from the case. But it’s not certain yet whether the chef who believes he’s a whistleblower will have to go to trial.
Norfolk Commonwealth’s Attorney Gregory Underwood will now handle the state embezzlement case of a former Executive Mansion chef. That’s because a Richmond circuit court judge has agreed to Attorney General Ken Cuccinelli’s request to withdraw from the case. But it’s not certain yet whether the chef who believes he’s a whistleblower will have to go to trial.
Todd Schneider’s lawyers argued that because the Attorney General knew of alleged improprieties between the Governor’s office and the CEO of nutritional supplements-maker Star Scientific, the Attorney General’s office should not have filed the charges against Schneider to begin with, and the case should be dismissed.
Judge Margaret Spencer delayed ruling on that until the new prosecutor can review the case. Schneider claims that Star Scientific CEO Jonnie Williams broke ethics laws by paying the catering bill for the wedding of McDonnell’s daughter.
The AG had asked to recuse himself, in part, because his office would face a conflict with state employees who may be called as witnesses. The next hearing has been set for May 14.
Senator Mark Obenshain Running for Attorney General
Posted by Virginia Public Radio in Candidate Profiles on May 3, 2013
 The two veteran state lawmakers and GOP candidates for Attorney General have spent the last several months energetically crisscrossing Virginia to win supporters. Republicans will choose one of them to be their nominee at the party’s state convention later this month. In part two of our election series, Virginia Public Radio’s Anne Marie Morgan reports on a State Senator from Harrisonburg who is carrying on his father’s legacy.
The two veteran state lawmakers and GOP candidates for Attorney General have spent the last several months energetically crisscrossing Virginia to win supporters. Republicans will choose one of them to be their nominee at the party’s state convention later this month. In part two of our election series, Virginia Public Radio’s Anne Marie Morgan reports on a State Senator from Harrisonburg who is carrying on his father’s legacy.
Delegate Robb Bell Running for Attorney General
Posted by Virginia Public Radio in Candidate Profiles on May 3, 2013
 On May 18th, Virginia Republicans will choose their party’s nominee for Attorney General at a statewide convention, and two veteran state lawmakers are vying for the job. In the first installment of our election series, Virginia Public Radio’s Anne Marie Morgan introduces us to one of those contenders: the lawmaker elected to Thomas Jefferson’s seat in the General Assembly, Delegate Rob Bell.
On May 18th, Virginia Republicans will choose their party’s nominee for Attorney General at a statewide convention, and two veteran state lawmakers are vying for the job. In the first installment of our election series, Virginia Public Radio’s Anne Marie Morgan introduces us to one of those contenders: the lawmaker elected to Thomas Jefferson’s seat in the General Assembly, Delegate Rob Bell.
UVA Salt Study
Posted by Virginia Public Radio in Virginia's News on May 3, 2013
Redshirting in Kindergarten
Posted by Virginia Public Radio in Virginia's News on May 2, 2013
If you’re a parent or grandparent with young children, you’ve probably heard about red-shirting – a term borrowed from the world of college sports. It refers to keeping a child back in school, so he or she will be a little older than classmates and have some academic and social advantages. Sandy Hausman reports a new study takes a close look at that practice, which concerns some educators.